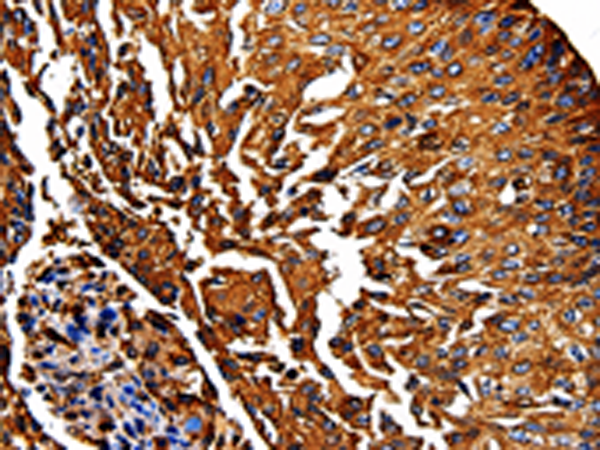

提醒成功

搜索
Rabbit Polyclonal Antibody to PKM
-
货号:
P00021 -
别名:
PK3; TCB; OIP3; PKM2; CTHBP; THBP1; HEL-S-30 -
应用:
WB,IHC -
反应种属:
Human, Mouse, Rat -
抗体类型:
Primary antibody -
Swissprot:
P14618 -
规格:
-
数量:
-+ -
说明书:
目录价¥1980

Rabbit Polyclonal Antibody to PKM
Description |
|---|
This gene encodes a protein involved in glycolysis. The encoded protein is a pyruvate kinase that catalyzes the transfer of a phosphoryl group from phosphoenolpyruvate to ADP, generating ATP and Stimulates POU5F1-mediated transcriptional activation. Plays a general role in caspase independent cell death of tumor cells. This protein has been shown to interact with thyroid hormone and may mediate cellular metabolic effects induced by thyroid hormones. This protein has been found to bind Opa protein, a bacterial outer membrane protein involved in gonococcal adherence to and invasion of human cells, suggesting a role of this protein in bacterial pathogenesis. |
Specification |
|
|---|---|
| Aliases | PK3; TCB; OIP3; PKM2; CTHBP; THBP1; HEL-S-30 |
| Swissprot | P14618 |
| WB Predicted band size | 58 kDa |
| Host/Isotype | Rabbit IgG |
| Antibody Type | Primary antibody |
| Storage | Store at 4°C short term. Aliquot and store at -20°C long term. Avoid freeze/thaw cycles. |
| Species Reactivity | Human, Mouse, Rat |
| Immunogen | Fusion protein of human PKM |
| Formulation | Purified antibody in PBS with 0.05% sodium azide and 50% glycerol. |
Application |
|
|---|---|
| WB | 1/500-1/2000 |
| IHC | 1/50-1/200 |
| ELISA | 1/500-1/5000 |
Product Image
- Gel: 8%SDS-PAGE, Lysate: 30 μg, Lane: Hela cells, Primary antibody: P00021(PKM Antibody) at dilution 1/500, Secondary antibody: Goat anti rabbit IgG at 1/8000 dilution, Exposure time: 5 seconds
- The image is immunohistochemistry of paraffin-embedded Human lung cancer tissue using P00021(PKM Antibody) at dilution 1/50. (Original magnification: ×200)
For Reseach Only
Application Key:WB - Western Blot | IHC - Immunohistochemistry | ICC - Immunocytochemistry | FCM - Flow Cytometry | ELISA - Enzyme-linked Immunosorbent Assay | IP - Immunoprecipitation
#P00021

相关产品















 微信/QQ登录
微信/QQ登录


 首页
首页